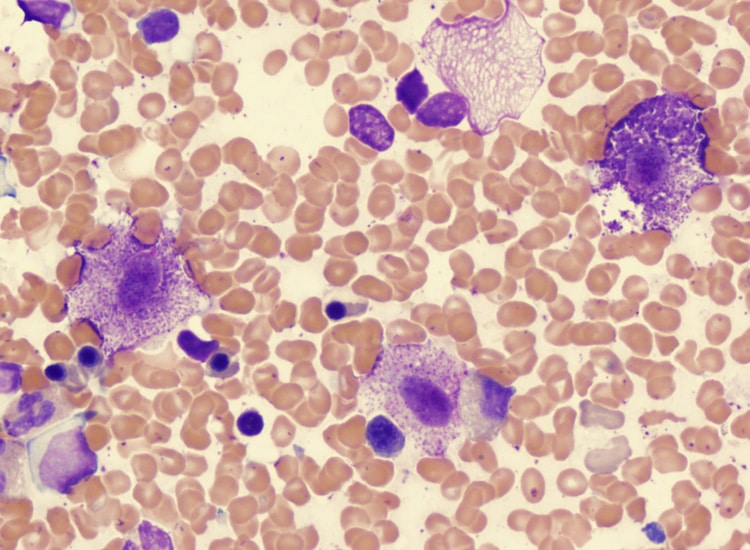

Mastocytome du chien : l’essentiel à savoir
✔ Le mastocytome est une tumeur maligne fréquente chez le chien, le plus souvent localisée dans la peau ou les tissus sous-cutanés.
✔ Cette tumeur peut prendre des aspects très variables : petit nodule, masse plus volumineuse, zone rouge, gonflée, ulcérée ou dépilée.
✔ Un mastocytome peut changer rapidement d’aspect après manipulation, en gonflant puis en diminuant de taille dans les heures qui suivent.
✔ Le diagnostic repose sur des prélèvements, comme une cytoponction ou une biopsie, afin de confirmer la nature tumorale et d’évaluer son agressivité.
✔ Le traitement repose principalement sur la chirurgie, parfois associée à la radiothérapie ou à la chimiothérapie selon le grade et l’extension de la tumeur.
✔ L’espérance de vie dépend surtout du grade de la tumeur, de sa localisation et de la présence éventuelle de métastases.
Mastocytome du chien : qu’est-ce que c’est ?
Définition des mastocytes
Les mastocytes sont des cellules qui font partie des globules blancs et sont présentes dans le sang. Ils sont essentiellement localisés dans les tissus conjonctifs, des tissus situés entre les différents organes et qui ont pour fonction de soutenir et de protéger les autres tissus de l’organisme. Les mastocytes jouent un rôle essentiel dans la défense immunitaire lorsqu’ils sont en présence d’une bactérie ou d’un parasite.
Observation de mastocytes (en violet) au microscope
Les mastocytes sont présents dans tous les organes du chien et principalement dans la peau ou les tissus sous-cutanés, les muqueuses, les poumons, le tube digestif (bouche, œsophage, estomac, intestin grêle, colon et anus) et le foie.
Les cellules sont de forme variable, constituées d’un noyau central et d’un cytoplasme (région entre la membrane et le noyau) rempli de nombreuses granulations colorées en violet foncé.
Description du mastocytome chez le chien
Le mastocytome, encore appelé tumeur mastocytaire ou MCT est une tumeur maligne, très fréquente chez le chien âgé. Elle représente entre 1 à 10% des tumeurs chez le chien et 20% des tumeurs cutanées.
Le mastocytome a généralement le derme de la peau pour origine et consiste en une prolifération tumorale des mastocytes. C’est une tumeur maligne car ses cellules cancéreuses peuvent se propager à d’autres parties du corps, comme les ganglions lymphatiques, la rate, le foie, la moelle osseuse et plus rarement le sang : on parle alors de métastases.

Mise en évidence au microscope d’une prolifération de mastocytes tumoraux chez un chien
Localisation du mastocytome chez le chien
On peut retrouver ainsi le mastocytome en divers endroits du corps du chien :
• Très fréquemment au niveau de la peau ou dans le tissu sous-cutané : en particulier sur le tronc (thorax, abdomen et bassin), l’arrière main et les extrémités de la patte.
• Plus rarement au niveau de la tête et du cou.
Les mastocytomes ont un aspect très variable. Au niveau de la peau, la tumeur se manifeste par l’apparition d’un nodule de 1 à 10 cm pouvant évoluer vers une masse plus volumineuse. La tumeur est unique dans la plupart des cas, mais elle peut également se présenter de façon multiple, ce qui est le cas pour 10% des chiens.
Les nodules peuvent être surélevés, provoquer une alopécie de la peau (perte de poils), un œdème, une rougeur ou une ulcération de l’épiderme. A la palpation, la tumeur peut être œdémateuse (gonflée et molle) ou ferme.
Lors de tumeur à croissance rapide, les cellules tumorales se diffusent souvent dans les tissus sous-cutanés et les muscles.

Mastocytome accompagné d’un œdème et d’une ulcération chez un chien
Certains mastocytomes sont agressifs dès leur apparition, d’autres peuvent être présents depuis plusieurs mois, voire quelques années avant de se disséminer rapidement dans l’organisme.
Le mastocytome concerne surtout les chiens adultes et âgés (9 ans en moyenne) mais il peut également toucher des chiens beaucoup plus jeunes. La tumeur a par exemple été observée chez des chiens de 6 mois.
Certaines races de chiens sont prédisposées au mastocytome, comme le Boxer, le Bulldog Anglais, le Bullmastiff, le Golden Retriever, le Labrador Retriever, le Setter Anglais, le Teckel ou le Terrier de Boston.

Mastocytome sur la patte d’un chien Labrador Retriever
![]()
Symptômes du mastocytome chez le chien
Les symptômes varient en fonction du grade (ou agressivité) et de la localisation de la tumeur. Cependant, dans tous les cas, il est possible d’observer des vomissements ou des diarrhées associés.
Une des caractéristiques du mastocytome est la modification de son aspect lorsque le maître manipule la masse : la tumeur peut grossir rapidement puis diminuer de taille dans les 24 heures suite à la palpation. Ce phénomène est expliqué par la dégranulation des mastocytes tumoraux. Cette dégranulation se manifeste par la libération d’histamine et provoque une inflammation puis la formation d’un urticaire au niveau de la peau.

Mastocytome ayant « dégonflé » sur la cuisse d’un chien Welsh Springer Spaniel
![]()
Quand consulter un vétérinaire ?
Une consultation est recommandée si :
• Vous remarquez une boule ou un nodule sur la peau de votre chien, même petit.
• La masse grossit rapidement, change d’aspect ou devient rouge, gonflée ou ulcérée.
• La tumeur semble varier de taille après palpation.
• Votre chien présente des vomissements, des diarrhées ou une baisse d’état général en plus d’une masse cutanée.
• Votre chien perd du poids, mange moins ou paraît affaibli pendant ou après le diagnostic.
• Un mastocytome a déjà été retiré et une nouvelle masse apparaît.
![]()
Diagnostic du mastocytome chez le chien
Analyse du mastocytome
Le vétérinaire effectue des prélèvements afin de réaliser un diagnostic précis :
• Par cytoponction : en aspirant des cellules tumorales au moyen d’une seringue et d’une aiguille. La ponction se fait directement dans la masse cutanée.
• Par biopsie : en prélevant un fragment de tissu de la tumeur sous anesthésie générale.
Les prélèvements récupérés sont ensuite analysés et examinés au microscope dans un laboratoire d’histologie afin de déterminer si la tumeur est cancéreuse ou non.

Mastocytome cutané sur le poitrail d’un chien Boxer
Clasification du mastocytome
En cas de tumeur maligne, l’histologie permet de préciser :
Le type de cellules concernées
Les mastocytes sont les seules cellules rondes à contenir des granulations colorées en violet, contrairement à d’autres cellules rondes à l’origine de lymphome ou de mélanome par exemple.
Le grade de la tumeur
Le grade détermine l’agressivité de la tumeur, provoquant la formation plus ou mois rapide de métastases dans l’organisme. Le grade est fortement corrélé au taux de récidive et à l’espérance de vie du chien.
Plus la ressemblance des cellules cancéreuses est proche du tissu d’origine, plus le grade est bas : la tumeur évolue alors localement et lentement et a moins de risque de métastaser dans d’autres organes.
Plus la ressemblance des cellules cancéreuses est différente du tissu d’origine, plus le grade est élevé : la tumeur se développe et métastase dans d’autres organes plus rapidement. Son pronostic est mauvais.
Selon le grading de Patnaik, il existe 3 grades histologiques notés de I à III et déterminant l’agressivité de la tumeur.
Le stade d’avancement du cancer
Le stade d’avancement correspond au degré d’extension de la tumeur dans l’organisme, le stade final étant la formation de métastases dans les autres organes.
Stade 1
Naissance de la tumeur sous la peau du chien (dans la couche du derme).
Stade 2
La tumeur grossit localement et forme un petit nodule sur la peau.
Stade 3
La tumeur envahit les tissus avoisinants (muscles, os…).
Stades 3 et 4
La masse devient rouge. Un œdème puis une ulcération peuvent apparaître.
Stade 4
Des cellules tumorales se disséminent dans le sang pour produire des métastases dans d’autres organes du corps…

Des examens complémentaires sont souvent réalisés : des analyses de sang, une ponction des noeuds (ou ganglions) lymphatiques, une ponction de moelle osseuse, une échographie abdominale et des radiographies pulmonaires.
![]()
Traitement du mastocytome chez le chien
Le vétérinaire choisit le traitement le mieux adapté en fonction du grade de la tumeur et de son stade d’avancement, déterminant la présence ou non de métastases dans l’organisme.
Les traitements possibles sont la chirurgie, la radiothérapie et la chimiothérapie, qui pourront être effectuées ensemble ou séparément.

Mastocytome sur la lèvre d’un chien Labrador Retriever
Chirurgie du mastocytome
La chirurgie est envisagée quand cela est possible. Elle est indiquée si la tumeur est de bas grade : bien localisée, peu agressive, petite, unique et opérée précocement.
Le retrait chirurgical doit s’opérer sur une large surface, concernant la lésion elle-même et le tissu environnant. La tumeur est retirée avec une marge de tissu sain de 3 cm minimum. Les tissus enlevés sont analysés afin de déterminer si l’exérèse, c’est-à-dire le retrait de la tumeur, a été complète.
Cependant, même avec une approche chirurgicale agressive, plus de 30% des mastocytomes récidivent après la chirurgie. Une radiothérapie en complément de la chirurgie peut alors être envisagée afin de réduire les risques de récidives.
Radiothérapie du mastocytome
La radiothérapie est indiquée seule ou suite à une chirurgie.
La radiothérapie consiste à détruire les cellules cancéreuses en envoyant des rayons, bloquant ainsi leur capacité à se multiplier. L’irradiation détruit les cellules tumorales tout en épargnant les tissus qui l’entourent.
Pour les tumeurs de grade I
Lorsque le retrait du mastocytome est total, la radiothérapie en complément de la chirurgie peut être pratiquée et permet de réduire au maximum les risques de récidives. Il s’agit d’une radiothérapie dite adjuvante qui, après le retrait de la tumeur, est effectuée afin d’éliminer les éventuelles cellules cancéreuses subsistant localement.
Pour les tumeurs de grade II
La radiothérapie permet d’irradier la tumeur restante lorsque la chirurgie ne permet pas de retirer le mastocytome dans sa totalité.
Pour les tumeurs de grade III
Lorsque des métastases se sont déjà formées, une radiothérapie seule ou en complément de la chirurgie peut être pratiquée afin d’améliorer la qualité de vie du chien. Une chimiothérapie peut être envisagée en complément.
Chimiothérapie du mastocytome
La chimiothérapie désigne l’administration de médicaments qui agissent sur les cellules cancéreuses. Le traitement a pour but de détruire les cellules ou de stopper leur multiplication.
La chimiothérapie est utilisée seule ou en complément de la chirurgie et/ou de la radiothérapie, lorsque des métastases sont présentes dans l’organisme.
Ce sont des traitements essentiellement palliatifs* afin d’améliorer le confort du chien.
* Traitements palliatifs : soins qui visent à atténuer les symptômes d’une maladie dont l’affection ne répond plus au traitement curatif.

Séance de chimiothérapie chez un chien Berger Australien
![]()
Espérance de vie du chien avec un mastocytome
L’espérance de vie d’un chien atteint d’un mastocytome varie en fonction de sa localisation et de son grade dans l’organisme.
La localisation du mastocytome
Par exemple, le temps de rémission et l’espérance de vie du chien sont meilleurs pour un mastocytome localisé aux extrémités (des pattes) que pour une tumeur située sur le tronc (thorax, abdomen ou bassin).
Une tumeur des régions inguinale (entre l’abdomen et la cuisse) ou périnéale (entre les organes génitaux et l’anus) a un pronostic sombre quel que soit son grade.
Le grade du mastocytome
Le grade détermine l’agressivité de la tumeur, provoquant la formation plus ou mois rapide de métastases dans l’organisme. Le grade est fortement corrélé au taux de récidive de la tumeur, à la présence de métastases et à l’espérance de vie du chien.
Taux de récidive
Le taux de récidive de la tumeur est de :
• 25 à 33% pour une tumeur de grade I.
• 44% pour une tumeur de grade II.
• 76% pour une tumeur de grade III.
Métastases
La fréquence des métastases est de :
• Moins de 10% pour une tumeur de grade I.
• 30 à 40% pour une tumeur de grade II.
• 55 à 96% pour une tumeur de grade III.
Espérance de vie
L’espérance de vie du chien à 4 ans après une intervention chirurgicale est de :
• 93% pour une tumeur de grade I.
• 44% pour une tumeur de grade II.
• 6% pour une tumeur de grade III.

Mastocytome cutané sur le menton d’un chien Yorkshire
![]()
Alimentation du chien atteint d’un mastocytome
L’alimentation joue un rôle très important dans la récupération de votre chien. Un nouveau régime alimentaire devra alors être mis en place afin de renforcer son système immunitaire et l’aider à combattre le mastocytome.
Il est très probable que celui-ci perde l’appétit et qu’il boude sa gamelle lorsqu’il sera sous traitement médical. Deux tiers des chiens environ perdent du poids lorsqu’ils sont atteints d’un cancer et présentent une fonte musculaire importante. Or plus le chien est affaibli, moins il aura de force pour combattre le mastocytome. Il est alors très important de bien surveiller la prise alimentaire et d’inciter votre chien à manger en lui proposant une alimentation attirante et appétissante.
Pourquoi est-il important que mon chien ait de l’appétit ?
• Cela permettra à votre chien de mieux supporter les traitements.
• Cela contribuera à améliorer sa qualité de vie.
• Ses défenses immunitaires seront renforcées, ce qui permettra à son organisme de mieux combattre le mastocytome.
• La médiane de survie sera supérieure si son état corporel est satisfaisant. Il vivra plus longtemps !
Il faut savoir que les chiens cancéreux présentant une perte de poids de plus de 6% ont une durée de vie réduite, quel que soit le traitement entrepris.
Pourquoi un nouveau régime alimentaire ?
Couvrir ses nouveaux besoins
Le processus tumoral entraîne des perturbations métaboliques qui modifient les besoins nutritionnels et énergétiques du chien. Il est donc impératif de couvrir ses besoins de base tout en répondant aux exigences liées au processus tumoral.
Le nourrir sans nourrir le lymphome
Les cellules tumorales ont besoin de nutriments pour se développer. Pour cela, elles détournent ceux-ci aux dépens de l’organisme de votre chien. L’objectif du nouveau régime alimentaire est donc de privilégier les nutriments qui ne sont pas utilisés par les cellules tumorales et de réduire ceux qui constituent leur carburant principal pour se développer.
Quel doit être le nouveau régime alimentaire ?
Une alimentation appétente, riche en nutriments essentiels, saine et équilibrée, avec une haute teneur en protéines et en bonnes matières grasses permettra à votre chien de garder un poids optimal, de conserver sa masse musculaire, d’améliorer sa qualité de vie, de combler ses besoins nutritionnels et enfin d’augmenter son espérance de vie.
Un nouveau régime alimentaire doit ainsi être déterminé et prendre en compte différents paramètres comme le poids actuel de votre chien, sa prise alimentaire, des troubles digestifs éventuels, son activité, le type de tumeur l’affectant (un mastocytome dans le cas présent)…
Les produits devant être de très bonne qualité, l’idéal est de préparer soit-même les repas de son chien. Pour cela, vous pouvez faire appel à un vétérinaire nutritionniste qui vous aidera à élaborer une ration ménagère répondant parfaitement aux besoins de votre chien.
Il existe cependant des alternatives pour les propriétaires pouvant difficilement élaborer une ration ménagère, faute de temps ou par peur de mal faire :
1 • L’aliment thérapeutique Recovery
L’aliment diététique Recovery de Royal Canin est adapté aux besoins du chien cancéreux et se présente sous forme de pâtée. Il s’agit d’un aliment thérapeutique qui possède une haute densité énergétique, il est très appétent pour le chien malade qui a besoin de reprendre de l’appétit.
Nous vous déconseillons fortement les produits de la grande distribution, et en particulier les produits premier prix qui auront des effets néfastes sur la santé de votre chien.
2 • L’alimentation fraîche Dog Chef
Il vous est possible de vous tourner vers un traiteur canin, comme le site Dog Chef qui élabore des repas pour les chiens cancéreux. Ce sont des rations sur-mesure, appétentes, fraiches, de qualité égale à l’alimentation humaine et élaborées par des vétérinaires nutritionnistes. De plus, elles sont livrées à domicile.
Pourquoi mon chien ne veut-il plus manger ?
Différentes raisons peuvent expliquer une perte d’appétit chez votre chien :
• Cela peut être dû au traitement qui est très lourd. La chimiothérapie ou la radiothérapie par exemple peuvent être responsables de troubles digestifs ou d’altérations du goût.
• Lorsque la tumeur atteint la cavité buccale, elle peut provoquer une gêne et une douleur lors de la prise alimentaire.
• Lorsque la tumeur atteint le tube digestif, elle peut perturber son bon fonctionnement.
• Des symptômes inhabituels provoqués par le mastocytome peuvent être à l’origine d’une baisse, voire d’un arrêt total de la prise alimentaire.
• Lorsque le chien est hospitalisé, le stress peut également avoir un impact sur son appétit.
Comment donner de l’appétit à mon chien ?
1 • Rajoutez à sa nourriture quelques petits morceaux de viande crue ou un bouillon de poulet (ou de bœuf) peu salé ou un peu d’huile d’olive.
2 • Préparez-lui des rations ménagères avec des ingrédients frais qui sont beaucoup plus savoureux et appétents ou bien faites appel à un traiteur canin comme Dog Chef si votre emploi du temps ne vous le permet pas.
3 • Réchauffez ses repas afin d’exalter certains arômes.
4 • Certains chiens peuvent refuser une alimentation solide car ils l’assimilent aux nausées et vomissements. Il est alors possible d’avoir recours à une alimentation liquide. Vendu par Royal Canin, Recovery Liquid est un aliment diététique complet que votre chien pourra prendre spontanément dans sa gamelle ou que vous pourrez lui faire avaler grâce à une seringue.
5 • Il est également possible de faire prendre à votre chien le complément alimentaire Nutribound qui stimule la prise alimentaire. Vendu par les laboratoires Virbac, Nutribound est une solution orale très appétente qui stimule l’appétit et qui est régulièrement utilisé par les vétérinaires pour traiter l’anorexie chez le chien au cours d’un cancer.
6 • Dans les cas extrêmes, l’alimentation du chien peut être effectuée par sonde buccale (par la bouche) ou naso-œsophagienne (par le nez) avec l’aliment liquide Recovery Liquid de Royal Canin.

Alimentation d’un chien Coton de Tuléar par sonde naso-œsophagienne
![]()
Questions fréquentes
Qu’est-ce qu’un mastocytome chez le chien ?
Le mastocytome est une tumeur développée à partir des mastocytes, des cellules impliquées dans les défenses immunitaires. Chez le chien, cette tumeur touche surtout la peau et le tissu sous-cutané. Elle est considérée comme maligne, car elle peut parfois envahir les tissus voisins ou se propager à d’autres organes.
Quels sont les symptômes d’un mastocytome ?
Le signe le plus fréquent est l’apparition d’une masse cutanée, unique dans la majorité des cas. Cette masse peut être ferme ou molle, avec ou sans perte de poils, rougeur, œdème ou ulcération. Certains chiens présentent aussi des vomissements ou des diarrhées. Un signe assez caractéristique est le fait que la masse puisse gonfler après manipulation puis diminuer ensuite.
Comment le vétérinaire confirme-t-il le diagnostic ?
Le vétérinaire réalise généralement une cytoponction, c’est-à-dire un prélèvement de cellules avec une aiguille fine, ou une biopsie sous anesthésie. L’analyse au microscope permet de confirmer qu’il s’agit bien d’un mastocytome. Elle permet aussi de préciser le grade tumoral, c’est-à-dire son niveau d’agressivité, ainsi que le risque de dissémination.
Quels sont les traitements possibles ?
La chirurgie est le traitement de référence lorsque la tumeur peut être retirée dans de bonnes conditions. Elle consiste à enlever la masse avec une marge de tissu sain autour. Selon les résultats d’analyse, la radiothérapie peut être proposée pour limiter les récidives locales. La chimiothérapie est plutôt utilisée lorsque la tumeur est agressive ou que des métastases sont déjà présentes.
Quelle est l’espérance de vie d’un chien atteint d’un mastocytome ?
Elle varie fortement selon le grade histologique et la localisation de la tumeur. D’après les données de l’article, la survie à 4 ans après chirurgie est de 93 % pour un grade I, 44 % pour un grade II et 6 % pour un grade III. Les tumeurs situées sur les extrémités ont en général un meilleur pronostic que celles localisées sur le tronc, la région inguinale ou périnéale.
L’alimentation a-t-elle un rôle important ?
Oui, l’alimentation est importante pour aider le chien à conserver son poids, sa masse musculaire et un bon état général. Un chien atteint d’un cancer peut perdre l’appétit, notamment à cause de la maladie ou des traitements. Une alimentation appétente, énergétique et bien équilibrée peut améliorer son confort et l’aider à mieux supporter les soins. Une ration ménagère formulée par un vétérinaire nutritionniste ou une alimentation diététique adaptée peut être envisagée.
Pourquoi mon chien atteint d’un mastocytome ne veut-il plus manger ?
La baisse d’appétit peut être liée aux traitements, aux nausées, à des troubles digestifs, à la douleur si la tumeur gêne la prise alimentaire, ou encore au stress d’une hospitalisation. Il est important de surveiller rapidement cette situation, car une perte de poids affaiblit le chien. Des solutions existent pour stimuler l’appétit, comme réchauffer les repas, proposer une alimentation plus appétente ou utiliser des aliments thérapeutiques adaptés.
![]()
Produits pouvant compléter ces conseils vétérinaires
Les produits présentés ci-dessous peuvent contribuer au bien-être du chien en complément des conseils vétérinaires exposés dans cet article.
Ils ne remplacent en aucun cas une consultation vétérinaire lorsque celle-ci est nécessaire.

Aliment thérapeutique possèdant une haute densité énergétique, très appétent, pour le chien malade ayant besoin de reprendre de l’appétit.

Rations sur-mesure, appétentes, fraiches, de qualité égale à l’alimentation humaine et élaborées par des vétérinaires nutritionnistes. Livrées à domicile.

Solution orale très appétente qui stimule l’appétit et qui est régulièrement utilisée par les vétérinaires pour traiter l’anorexie chez le chien au cours d’un cancer.

Protégez la santé de votre chien
Pour le protéger dans n’importe quelle situation, nous vous conseillons d’opter pour une assurance santé

N°1 de l’assurance santé animale
Références
Auteur de l’article
Docteur Laurence Dillière Lesseur, Vétérinaire Comportementaliste
Diplômée de l’École Nationale Vétérinaire d’Alfort.
Titulaire du Diplôme Inter-Ecoles de Vétérinaire Comportementaliste.
Cofondatrice du site Catedog.com.
Sources de l’article
• Moraillon R., Legeay Y., Boussarie D. et Sénécat O. Dictionnaire pratique de thérapeutique chien, chat et NAC. Editions Masson 2010.
• Hébert F. et Bulliot C. Guide pratique de médecine interne chien, chat, NAC.Editions Med’Com, 2010.
• Soyer C. et Doliger S. Vade-mecum, Cancérologie vétérinaire. Editions Med’Com, 2011.
• Cartagena Albertus J.C. Guide clinique de cancérologie du chien et du chat. Editions Le Point Vétérinaire, 2012.
• Vieillevigne V. et Parachini-Winter C. Cancérologie clinique du chat et du chien. Editions Le Point Vétérinaire, 2021.
• Atlas Vet’Consult Chirurgie. Editions Med’Com 2012.
• Mc Cracken T.O. et Kainer R.A. Atlas d’Anatomie du Chien, du Chat et des NAC Les Fondamentaux. Editions Med’Com, 2010.
Auteur des illustrations
Vincent Lesseur, web designer, graphiste, illustrateur
Cofondateur du site Catedog.com.
Auteurs des photos
• Vincent Lesseur
• Shutterstock
• Wikimedia Commons
Liens Amazon
Cet article contient des liens d’affiliation vers Amazon.
En tant que Partenaire Amazon, nous réalisons un bénéfice sur les achats remplissant les conditions requises.
Lien partenaire
Cet article contient un lien affilié vers Dog Chef.
Cela signifie que Catedog peut percevoir une petite commission si vous passez commande via ce lien, sans aucun surcoût pour vous. Cette rémunération ne modifie en rien l’indépendance de notre avis vétérinaire.







